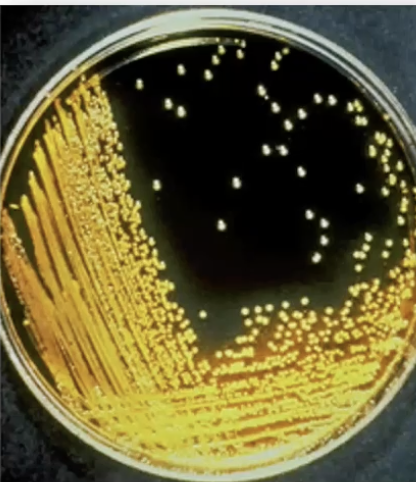
term image
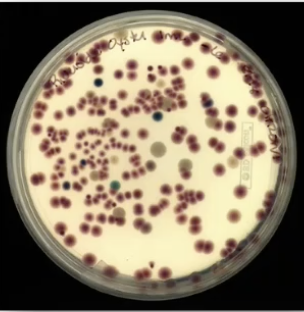
term image
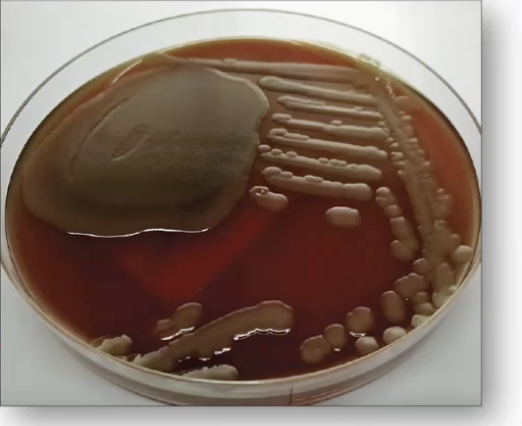
term image
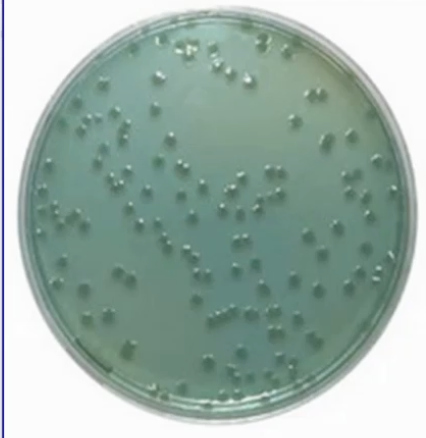
term image
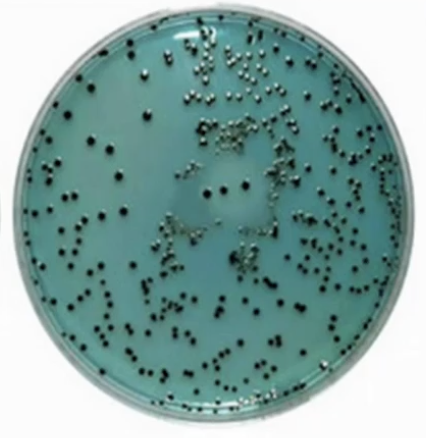
<p></p>
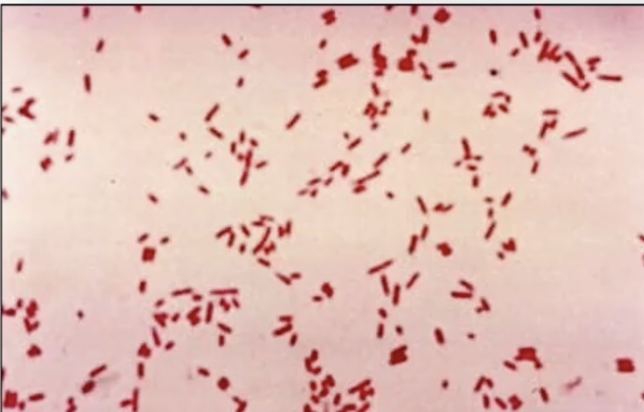
term image

Bacterial Photo I.D.
1/70
There's no tags or description
Looks like no tags are added yet.
Name | Mastery | Learn | Test | Matching | Spaced |
|---|
No study sessions yet.
71 Terms

Cervicofacial Actinomyces - Branching gram positive rod (anaerobic)

Actinomyces - Branching gram positive rod (anaerobic)

Actinomyces - Branching gram positive rod (anaerobic)

Actinomyces - Branching gram positive rod (anaerobic)

Actinomyces - Branching gram positive rod (anaerobic)

Actinomyces - Branching gram positive rod (anaerobic)

Actinomyces culture “Anchovy Paste”- Branching gram positive rod (anaerobic)

Nocardia - Branching gram positive rod (aerobic)

Nocardia - Branching gram positive rod (aerobic)

Nocardia - Branching gram positive rod (aerobic)

Nocardia - Branching gram positive rod (aerobic)

Haemophilus - Gram negative coccobacilli

Haemophilus - Gram negative coccobacilli

Haemophilus Influenzae - Gram negative coccobacilli

Haemophilus Ducreyi - Gram negative coccobacilli

Haemophilus Ducreyi - Gram negative coccobacilli

Bordatella - Gram negative coccobacilli

Bordatella Pertussis - Gram negative coccobacilli, motile encapsulated aerobe

Bordatella Pertussis - Gram negative coccobacilli, motile encapsulated aerobe

Bordatella Pertussis - Gram negative coccobacilli, motile encapsulated aerobe

Bordatella Pertussis - Gram negative coccobacilli, motile encapsulated aerobe

Bordatella Pertussis - Gram negative coccobacilli, motile encapsulated aerobe

Mycoplasma - No cell wall, gram negative and pleomorphic (no structure to make consistent shape)

Mycoplasma - No cell wall, gram negative and pleomorphic (no structure to make consistent shape) (M. Pneumoniae is photo)

Mycoplasma - No cell wall, gram negative and pleomorphic (no structure to make consistent shape) (M. Genitalium is photo)

Neisseria - Gram (-) diplococci with outer membrane LOS (lipo-oligosacchiride)

Neisseria Meningitides - Gram (-) diplococci with outer membrane LOS (lipo-oligosacchiride) AND polysaccharide capsule (serotypes A,B,C,Y,W-145)

Neisseria Gonorrhoeae - Gram (-) diplococci with outer membrane LOS (lipo-oligosacchiride) AND pili which shapeshift

Neisseria Gonorrhoeae - Gram (-) diplococci with outer membrane LOS (lipo-oligosacchiride) AND pili which shapeshift

Neisseria Gonorrhoeae from a male which is diagnostic - Gram (-) diplococci with outer membrane LOS (lipo-oligosacchiride) AND pili which shapeshift

Neisseria Gonorrhoeae from a female which is harder to tell - Gram (-) diplococci with outer membrane LOS (lipo-oligosacchiride) AND pili which shapeshift

Vibrio - Gram (-) rods, curved can be anaerobic (facultative)

Vibrio Cholerae - Gram (-) rods, curved can be anaerobic (facultative). Serotypes O1 and O139 produce toxin.
Special TCBS Stain showing Vibrio Cholerae - Gram (-) rods, curved can be anaerobic (facultative). Serotypes O1 and O139 produce toxin.

Vibrio Cholerae - Gram (-) rods, curved can be anaerobic (facultative). Serotypes O1 and O139 produce toxin.

Vibrio Cholerae - Gram (-) rods, curved can be anaerobic (facultative). Serotypes O1 and O139 produce toxin.

Vibrio Vulnificus - Gram (-) rods, curved. Extremely virulent, like cholera but causes seafood deaths and skin lesions

Vibrio Vulnificus - Gram (-) rods, curved. Extremely virulent, like cholera but causes seafood deaths and skin lesions
Vibrio Vulnificus - Gram (-) rods, curved. Extremely virulent, like cholera but causes seafood deaths and skin lesions
Vibrio Vulnificus - Gram (-) rods, curved. Extremely virulent, like cholera but causes seafood deaths and skin lesions

Campylobacter Jejuni - Gram (-) rods, curved, oxidase positive with CDT toxin causing cell arrest in G2 and cell death

Helicobacter Pylori- Gram (-) rods, curved, urease positive, CAG pathogenicity island produced CagA protein and sheathed flagella

Helicobacter Pylori - Gram (-) rods, curved, urease positive, CAG pathogenicity island produced CagA protein and sheathed flagella

Helicobacter Pylori - Gram (-) rods, curved, urease positive, CAG pathogenicity island produced CagA protein and sheathed flagella

Shigella Dysenteriae - Very infectious gram (-) rod that produces Stx

Shigella Dysenteriae - Very infectious gram (-) rod that produces Stx
Shigella Dysenteriae - Very infectious gram (-) rod that produces Stx
Salmonella Typhi - Gram (-) rod that produces stepwise fever

Escheria E. coli - Gram (-) rod that is lactose fermenting oxidase negative

Escheria E. coli - Gram (-) rod that is lactose fermenting oxidase negative

Escheria E. coli EPEC- Gram (-) rod that is lactose fermenting oxidase negative and causes A/E lesions and diarrhea in infants and secretes its own receptor

Escheria E. coli EAEC (O104:H4) - Gram (-) rod that is lactose fermenting oxidase negative and causes stacked brick on epithelial cells and chronic , non bloody diarrhea
Escheria E. coli - Gram (-) rod that is lactose fermenting oxidase negative

Pseudomonas Aeruginosa - Gram negative rod, oxidase positive, lactose non fermenting, pyocyanine and pyoverdine for green/blue coloration

Pseudomonas Aeruginosa - Gram negative rod, oxidase positive, lactose non fermenting, pyocyanine and pyoverdine for green/blue coloration

Legionella Pneumophila - Gram negative rod, lives inside macrophages or amoebas if still in natural environment of water, requires silver and immunofluorescence staining, oxidase and catalase positive

Legionella Pneumophila - Gram negative rod, lives inside macrophages or amoebas if still in natural environment of water, requires silver and immunofluorescence staining, oxidase and catalase positive

Yersinia Pestis - Gram negative rod of enterobacteriae family which is bipolar staining. Has glycoprotein capsule and is the causative agent for the bubonic plague

Francisella Tularensis - Gram negative rod, very infectious in hunters dealing with wild mammals, has a lipid rich capsule, hard to stain

Francisella Tularensis - Gram negative rod, very infectious in hunters dealing with wild mammals, has a lipid rich capsule, hard to stain

Treponema Pallidum - Gram negative spirochete which causes syphillis. Grown in special medium, slow, low oxygen conditions. Treated with penicillin

Treponema Pallidum - Gram negative spirochete which causes syphillis. Grown in special medium, slow, low oxygen conditions. Treated with penicillin

Treponema Pallidum - Gram negative spirochete which causes syphillis. Grown in special medium, slow, low oxygen conditions. Treated with penicillin (Rash of the palms and soles = Syphilis!!!!)

Treponema Pallidum - Gram negative spirochete which causes syphillis. Grown in special medium, slow, low oxygen conditions. Treated with penicillin

Treponema Pallidum - Gram negative spirochete which causes syphillis. Grown in special medium, slow, low oxygen conditions. Treated with penicillin

Treponema Pallidum - Gram negative spirochete which causes syphillis. Grown in special medium, slow, low oxygen conditions. Treated with penicillin. (Aortic aneurism and regurgitation)

Treponema Pallidum - Gram negative spirochete which causes syphillis. Grown in special medium, slow, low oxygen conditions. Treated with penicillin.

Treponema Pallidum - Gram negative spirochete which causes syphillis. Grown in special medium, slow, low oxygen conditions. Treated with penicillin.

Treponema Pallidum - Gram negative spirochete which causes syphillis. Grown in special medium, slow, low oxygen conditions. Treated with penicillin.

Treponema Pallidum - Gram negative spirochete which causes syphillis. Grown in special medium, slow, low oxygen conditions. Treated with penicillin